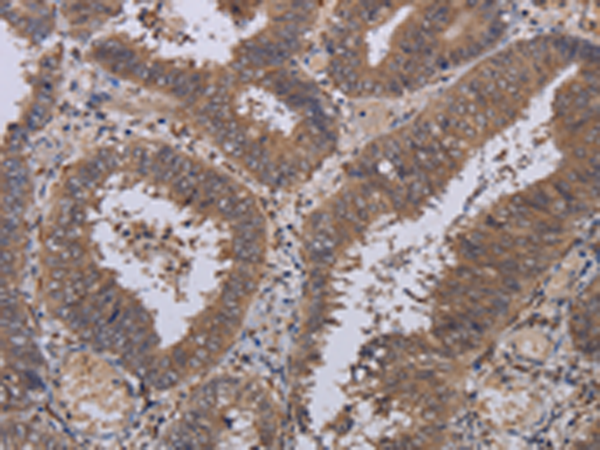

中文名稱: 兔抗P3H3多克隆抗體
英文名稱: Anti-P3H3 rabbit polyclonal antibody
別 名: prolyl 3-hydroxylase 3; GRCB; LEPREL2; HSU47926
相關(guān)類別: 一抗
儲(chǔ) 存: 冷凍(-20℃)
抗 原: P3H3
宿 主: Rabbit
反應(yīng)種屬: Human, Mouse
標(biāo) 記 物: Unconjugate
克隆類型: rabbit polyclonal
技術(shù)規(guī)格
|
Background: |
The protein encoded by this gene belongs to the leprecan family of proteoglycans, which function as collagen prolyl hydroxylases that are required for proper collagen biosynthesis, folding and assembly. This protein, like other family members, is thought to reside in the endoplasmic reticulum. Epigenetic inactivation of this gene is associated with breast and other cancers, suggesting that it may function as a tumor suppressor. [provided by RefSeq, Aug 2013] |
|
Applications: |
ELISA, IHC |
|
Name of antibody: |
P3H3 |
|
Immunogen: |
Fusion protein of human P3H3 |
|
Full name: |
prolyl 3-hydroxylase 3 |
|
Synonyms: |
GRCB; LEPREL2; HSU47926 |
|
SwissProt: |
Q8IVL6 |
|
IHC positive control: |
Human colon cancer and Human brain |
|
IHC Recommend dilution: |
50-200 |
購(gòu)物車(chē)
購(gòu)物車(chē) 幫助
幫助
 021-54845833/15800441009
021-54845833/15800441009
